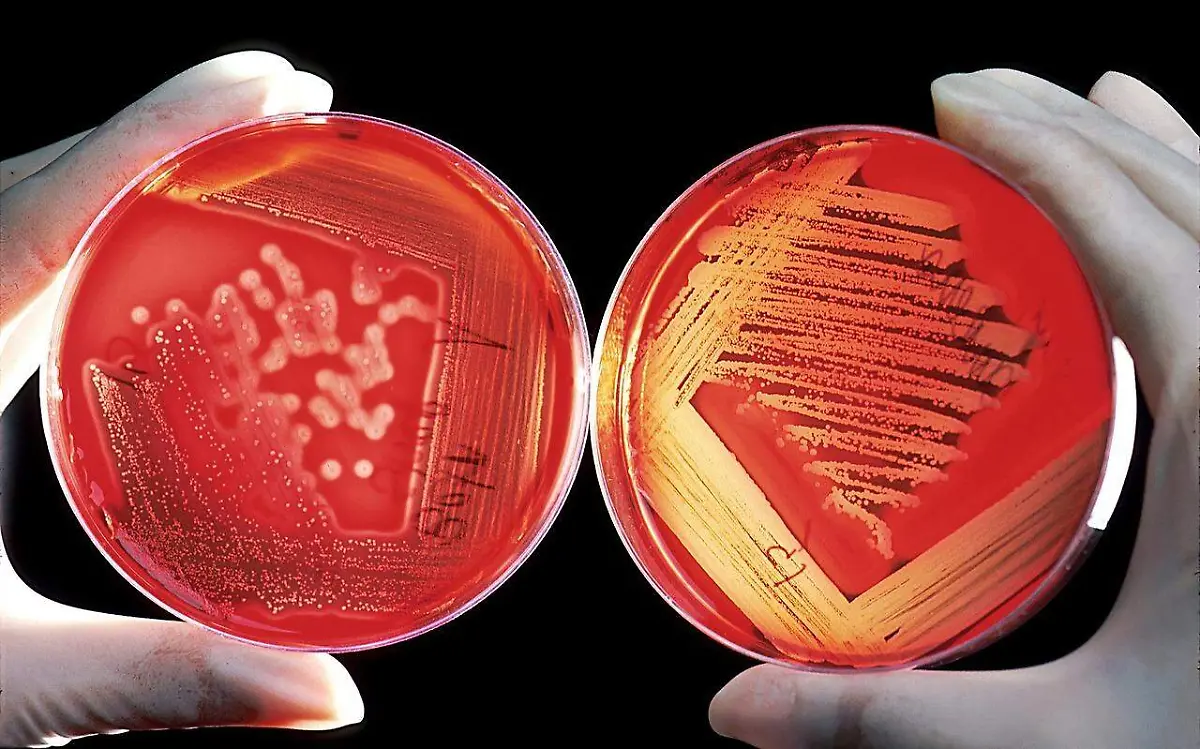

Localjueves, 25 de mayo de 2023
Tamaulipas demandará por brote de meningitis: hay cinco casos confirmados en México
El departamento jurídico del Gobierno del Estado de Tamaulipas está integrando la información para sustentar la denuncia por los contagios de meningitis